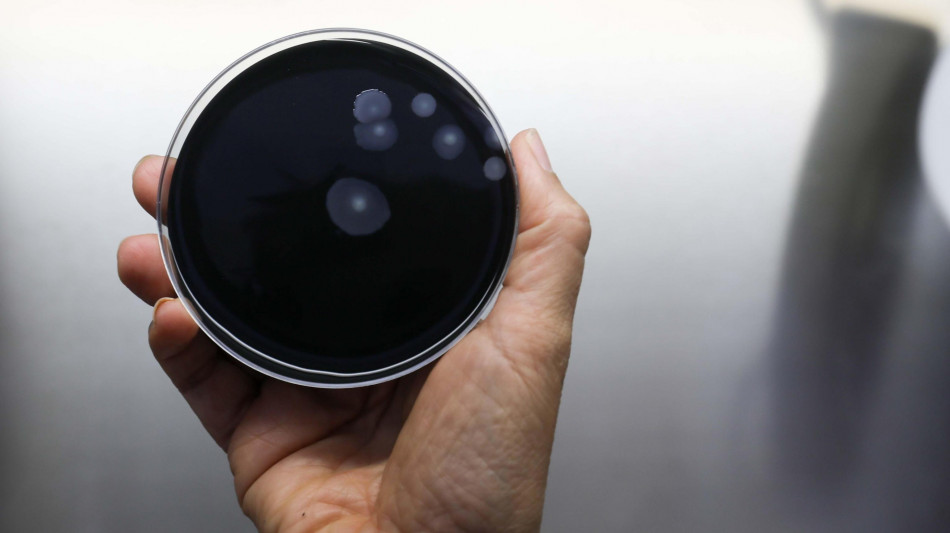
L'Iss in prima linea in Ue per il contrasto alla legionella

L'Iss in prima linea in Ue per il contrasto alla legionella
Via al progetto europeo per rafforzare e coordinare i laboratori
Rafforzare la sorveglianza e la capacità diagnostica dei laboratori europei nella lotta alla legionellosi per far fronte a quella che è una delle principali infezioni respiratorie trasmissibili a livello comunitario, con l'Organizzazione mondiale della sanità che l'ha individuata tra quelle che causa il maggiore onere sanitario nell'Unione europea. È questo l'obiettivo del progetto europeo Eurl-Ph-Legi, (European reference laboratory for Legionella diagnostic and laboratory surveillance), finanziato dalla Commissione europea nell'ambito del programma EU4Health e coordinato dalla European Health and Digital Executive Agency (Hadea), che vede l'Istituto superiore di sanità tra i partner e come coordinatore del gruppo che dovrà armonizzare i metodi di rilevamento e caratterizzazione del batterio. Nello specifico, il Laboratorio nazionale di riferimento per le legionelle partecipa come leader nei seguenti progetti: studio sui metodi Pcr (tecnica utilizzata per rilevare e quantificare il Dna di legionella in campioni di acqua o altri fluidi) attraverso la valutazione delle performance dei kit Pcr commerciali; organizzazione di riunioni della rete di laboratori; consulenza e supporto tecnico all'European Legionnaires' disease Surveillance Network; supporto all'Ecdc (European centre for disease prevention and control) in caso di epidemie. Inoltre, sono stati avviati: una survey rivolta ai laboratori europei per mappare i bisogni formativi e operativi in tema di diagnosi e sorveglianza; la stesura di un handbook tecnico; un pilot study di correlazione genomica tra ceppi di legionella; l'organizzazione della prima missione tecnica in Lituania, volta a raccogliere sul campo le necessità dei laboratori locali e promuovere il dialogo scientifico.
N.Behan--IP


